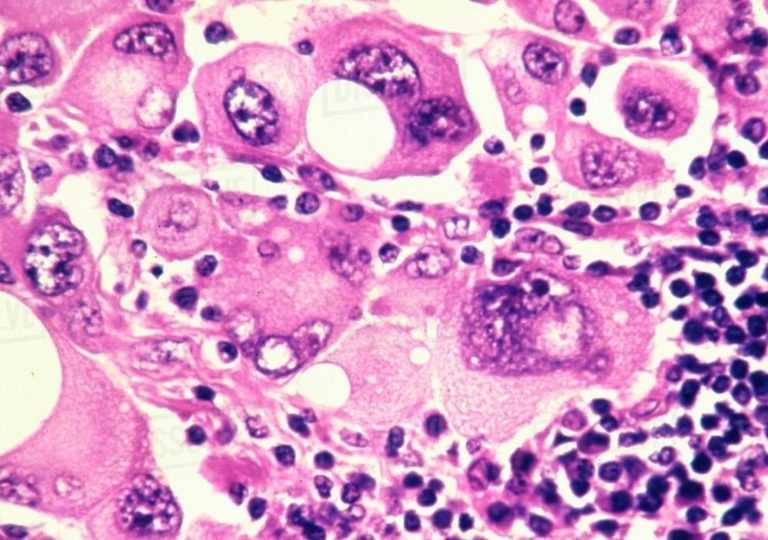

Η απελευθέρωση του ανοσοποιητικού συστήματος για την καταπολέμηση των όγκων – μια προσέγγιση που επιτρέπει η ανοσοθεραπεία – έχει οδηγήσει σε αξιοσημείωτα αποτελέσματα σε μερικούς καρκινοπαθείς, αλλά σε πολλά άλλα, τα καρκινικά κύτταρα αποφεύγουν τη θεραπεία και συνεχίζουν να εξαπλώνονται. Τώρα, μια ομάδα με επικεφαλής ερευνητές από το Broad Institute του MIT και του Χάρβαρντ και του Dana-Farber Cancer Institute έχει εντοπίσει ένα πρότυπο γονιδιακής έκφρασης που χρησιμοποιούν ανθρώπινα κύτταρα μελανώματος για να αντισταθούν στην ανοσοθεραπεία και κατέδειξαν μια προσέγγιση συνδυασμένης θεραπείας που θα μπορούσε να ξεπεράσει αυτή την αντίσταση.
Το έγγραφο, που δημοσιεύθηκε στο Cell, εμφανίζεται μαζί με μια συνοδευτική μελέτη ανοσοθεραπείας υπό την καθοδήγηση μιας ξεχωριστής ερευνητικής ομάδας από το Broad Institute και το Γενικό Νοσοκομείο της Μασαχουσέτης.
«Με πρόσθετα στοιχεία, ελπίζουμε ότι οι μέθοδοι και η συγκεκριμένη θεραπεία συνδυασμού που εντοπίστηκαν στη μελέτη μας θα μπορούσαν να έχουν πραγματικό όφελος για τους ασθενείς», δήλωσε ο συν-ανώτερος συντάκτης Benjamin Izar, εκπαιδευτής στον τομέα της ιατρικής και του μελανώματος ογκολόγος στο Dana-Farber Cancer Institute και postdoctoral συνάδελφός του στο Broad Institute. Αυτός και ο Aviv Regev, διευθυντής του Παρατηρητηρίου κυττάρων Klarman στο ευρύ ινστιτούτο, καθηγητής βιολογίας στο MIT, και ερευνητής της HHMI, είναι συν-ανώτεροι συγγραφείς στο έγγραφο.
«Η ομάδα μας έχει χαρτογραφήσει ένα τοπίο υψηλής ανάλυσης ανοσοθεραπευτικού μελανώματος,» πρόσθεσε ο Regev. «Έχουμε ανακαλύψει ένα πρόγραμμα έκφρασης γονιδίων που μπορεί να βοηθήσει στην πρόβλεψη αντοχής στην ανοσοθεραπεία πριν από την έναρξη της θεραπείας και έναν πιθανό τρόπο να αντιστραφεί αυτό το πρόγραμμα προκειμένου να καθυστερήσει ή να αντιμετωπιστεί αυτή η αντίσταση».
Χρησιμοποιώντας δεδομένα αλληλουχίας RNA ενός κυττάρου, οι ερευνητές ανέλυσαν χιλιάδες κύτταρα μελανώματος από περισσότερους από 30 ασθενείς με μελάνωμα, οι μισοί από τους οποίους είχαν παρουσιάσει αντίσταση στις ανοσοθεραπείες. Η ομάδα αναγνώρισε ένα ξεχωριστό πρότυπο έκφρασης γονιδίων το οποίο συσχετίζεται με μειωμένη παρουσία Τ κυττάρων στον όγκο και άλλα χαρακτηριστικά της ανοσοθεραπείας.
Μετρώντας τα επίπεδα αυτού του «προγράμματος αντίστασης» πριν από τη θεραπεία, η ομάδα θα μπορούσε να προβλέψει πώς οι όγκοι θα ανταποκρίνονταν στην ανοσοθεραπεία – αντιμετωπίζοντας έτσι μια σημαντική κλινική πρόκληση στον τομέα της ανοσο-ογκολογίας. Η ανάλυση αυτή έγινε σε μεγαλύτερες ανεξάρτητες ομάδες ασθενών με μελάνωμα, συναρμολογημένες σε συνεργασία με συναδέλφους στο Γενικό Νοσοκομείο της Μασαχουσέτης και στο Πανεπιστήμιο του Έσσεν στη Γερμανία. Και σε μια άλλη ομάδα ασθενών, η ομάδα έδειξε ότι τα καρκινικά κύτταρα ενισχύουν περαιτέρω αυτό το πρόγραμμα όταν εκτίθενται σε ανοσοθεραπεία.